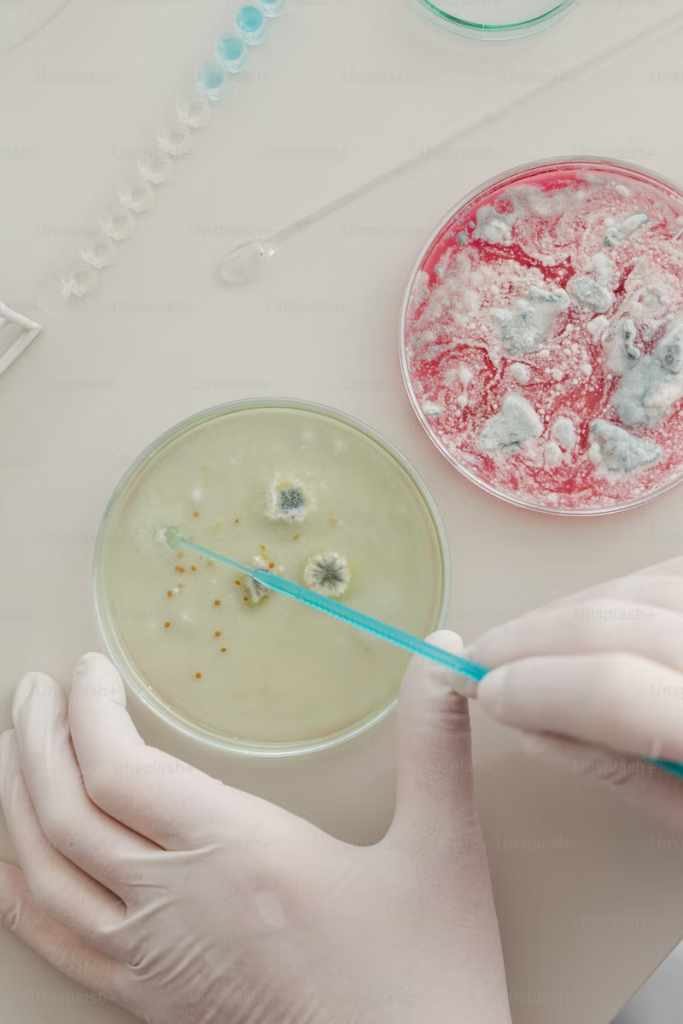
Balancing Chemistry and Compatibility in Modern Relationships

How to balance out both chemistry and compatibility in relationships? Here’s some tips and tricks for you
In the world of modern relationships, the pursuit of love often navigates the intriguing interplay between chemistry and compatibility. These two elements, while distinct, contribute significantly to the foundation of a successful and lasting partnership. Striking the right balance between the sparks of chemistry and the stability of compatibility is a journey that requires insight, communication, and a dash of self-awareness. In this article, we delve into the art of balancing these essential aspects to build strong and fulfilling relationships.
Casual or date, you decide. Download DOWN hookup app for IOS or DOWN Hookup App for Android.
Understanding Chemistry: The Spark That Ignites
Chemistry is often likened to a magnetic force that draws two individuals together. It’s that electrifying feeling you get when you meet someone and sparks fly. Chemistry can be intense and immediate, leading to a sense of connection and attraction that’s hard to ignore. However, it’s important to recognize that while chemistry can ignite a passionate flame, it doesn’t necessarily guarantee long-term compatibility.
The Role of Compatibility: The Building Blocks of Lasting Love
Compatibility, on the other hand, forms the foundation upon which a relationship can flourish over time. It encompasses shared values, life goals, communication styles, and the ability to work through challenges as a team. Compatibility provides the stability needed to weather the ups and downs that every relationship faces. It’s the glue that holds a couple together even when the initial spark of chemistry might dim.
Casual or date, you decide. Download DOWN hookup app for IOS or DOWN Hookup App for Android.
The Balancing Act: Fostering Both Chemistry and Compatibility
- Open Communication: The key to balancing chemistry and compatibility lies in open and honest communication. Discuss your values, interests, and aspirations early on to gauge whether you’re aligned for the long haul.
- Invest in Getting to Know Each Other: While chemistry can feel intoxicating, take the time to truly know your partner beyond the surface. Engage in deep conversations that reveal your dreams, fears, and shared experiences.
- Acknowledge Differences: It’s okay to have differences, but understanding how they align with your compatibility is crucial. Healthy compromise and mutual respect play a significant role in maintaining the balance.
- Build a Friendship: A strong friendship is the backbone of compatibility. Nurture your emotional connection and friendship by spending quality time together and being supportive.
- Plan for the Future: Consider your long-term goals individually and as a couple. Compatibility shines when you’re both striving for similar life paths.
- Don’t Disregard Red Flags: Chemistry might make us overlook potential issues, but compatibility requires a sober assessment of whether your values and goals align.
- Keep the Spark Alive: As the initial chemistry evolves, find ways to keep the flame burning. Surprise each other, explore new activities, and engage in shared hobbies.
- Embrace Growth Together: A relationship should encourage personal growth for both partners. Embrace change and challenges as opportunities to strengthen compatibility.
Casual or date, you decide. Download DOWN hookup app for IOS or DOWN Hookup App for Android.
Final Thoughts
Balancing chemistry and compatibility is a delicate dance that requires self-awareness, patience, and a willingness to evolve. While chemistry can set your heart racing, compatibility gives your love a sturdy foundation to withstand the test of time. Strive for a relationship that encapsulates the electrifying sparks of chemistry while resting on the steadfast ground of compatibility. When these two forces harmonize, you’re well on your way to creating a love story that stands the test of modern times.
More posts:
25 Irresistible Smooth Pick-Up Lines To Rizz You Up
18+Dirty Pick-Up Lines For Girls to Heat Him Up
20 Best Funny Pick Up Lines – Inspired by “Never Have I Ever” On Netflix